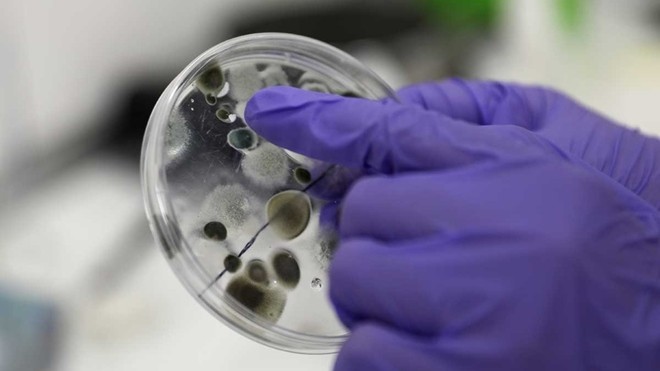

MUNDO
21 de diciembre de 2020
Qué se sabe de la mutación "N5017", la nueva cepa del coronavirus
Afirman que además de propagarse más rápido, se está convirtiendo en "dominante"
La nueva cepa de coronavirus, "N5017",se trata de una variante más contagiosa. Asimismo, aseguran que además de propagarse más rápido, se está convirtiendo en "dominante". Sin embargo, señalan que no hay pruebas de que haya aumentado la gravedad de la enfermedad y remarcan que las vacunas son eficaces para combatirla. Preocupa la capacidad hospitalaria para atender pacientes. Recomiendan continuar con los cuidados básicos para evitar su propagación.
La mutación, denominada "N5017", le permite engancharse a las células humanas para penetrarlas. Recomiendan continuar con los cuidados básicos para evitar su propagación.
Patrick Vallance, consejero científico del gobierno británico, indicó el sábado que esta nueva variante del SARS-CoV-2, además de propagarse rápidamente, se estaba convirtiendo en la forma "dominante", lo que conllevó "una subida muy fuerte" de los ingresos hospitalarios en diciembre. La nueva cepa habría aparecido a mediados de septiembre en Londres o en Kent (sureste), según él.
El médico-jefe de Inglaterra, Chris Whitty, en un comunicado, informó: "El grupo consultivo sobre amenazas nuevas y emergentes de virus respiratorios (NERVTAG) considera que esta nueva cepa puede propagarse más rápidamente". Sin embargo, "nada indica, de momento, que esta nueva cepa cause una tasa de mortalidad más alta o que afecte a las vacunas y los tratamientos, pero se están realizando trabajos de forma urgente para confirmar eso".
El profesor de Medicina Paul Hunter, de la Universidad de East-Anglia, citado en la página web de Science Media Centre, precisó que esta idea se basa en la constatación de "un aumento muy fuerte de casos de contagio y de hospitalizaciones en Londres y en el sureste, respecto al resto de Inglaterra, en los últimos días". "Este aumento parece estar causado por la nueva cepa", añadió, en alusión a las informaciones aportadas por las autoridades sanitarias.
El profesor Peter Openshaw, señaló que la información "sobre esta nueva cepa es muy preocupante". Sobre todo, porque "parece ser entre un 40% y un 70% más transmisible", añadió el inmunólogo del Imperial College de Londres, citado por Science Media Centre.
Desde la London School of Hygiene & Tropical Medicine, el profesor John Edmunds, manifestó: "Es una muy mala noticia". "Parece que este virus es mucho más infeccioso que la cepa precedente".
El genetista francés Axel Kahn recordó, su página de Facebook, que, hasta ahora, "se han secuenciado 300.000 mutantes del SARS-CoV-2 en el mundo".
La nueva cepa incorpora una mutación, llamada "N5017", en la proteína de la "espícula" del coronavirus, que le permite engancharse a las células humanas para penetrarlas.
En tanto que el doctor Julian Tang, de la Universidad de Leicester, indicó que "esta mutación N5017 ya circulaba mucho antes, de forma esporádica, este año fuera del Reino Unido, en Australia en junio-julio, en Estados Unidos en julio y en Brasil en abril".
"Los coronavirus mutan todo el tiempo, así que no es sorprendente que emerjan nuevas variantes del SARS-CoV-2", recordó el profesor Julian Hiscox, de la Universidad de Liverpool. "Lo más importante es intentar saber si esa variante tiene propiedades que impactan en la salud de los humanos, los diagnósticos y las vacunas".
Axel Kahn agregó: "Cuantos más virus haya y, por ende, más personas afectadas, más mutaciones aleatorias habrá" que sean "ventajosas para el virus".
De acuerdo con la Organización Mundial de la Salud (OMS), además de "los indicios preliminares de que la variante podría ser más contagiosa", la cepa en cuestión "también podría afectar a la eficacia de algunos métodos de diagnóstico", eso sí, "según informaciones preliminares".
Pero, "no hay ninguna prueba de algún cambio en la gravedad de la enfermedad", aunque esa cuestión también se está investigando.
La confirmación del nivel de transmisibilidad de esta cepa llevó a las autoridades británicas a decretar un nuevo confinamiento en Londres y en parte de Inglaterra, que afecta a un total de 16 millones de habitantes.
A la vez que la OMS instó a sus miembros en Europa a "reforzar sus controles". Fuera del territorio británico, se detectaron nueve casos en Dinamarca, uno en Holanda y otro en Australia, según la OMS.
El Centro Europeo de Control de Enfermedades (ECDC), que integra a una treintena de países, incluyendo a los miembros de la UE y al Reino Unido, no "descartó" que la variante esté circulando ya fuera del territorio británico.
El domingo Holanda y Bélgica, suspendieron todos los vuelos de pasajeros provenientes del Reino Unido, mientras Italia, Rumania y Alemania también anunciaron que cesarán momentáneamente las conexiones aéreas.
No obstante, esta lista no es exhaustiva, pues numerosos gobiernos europeos están estudiando la posibilidad de adoptar medidas parecidas.
Por su parte Berlín también prepara restricciones a las conexiones aéreas con Sudáfrica, donde se detectó la misma cepa del virus. En Alemania, el ministro de Salud, Jens Spahn, dio a conocer las impresiones de los expertos de las autoridades europeas, que en las últimas horas debatieron respecto a la mutación registrada en Gran Bretaña. Siguen siendo "igual de eficaces", dijo.
#QuedateEnCasa y mantenete informado, escuchá La 97.1 todo el día, hacé click acá
📻
Descarga la App de #RTuc haciendo click acá
📲​
Seguinos en Youtube






